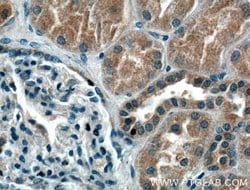
SIRT2 Mouse anti-Human, Mouse, Porcine, Rat, Clone: 1D8G10, Proteintech

missing translation for 'onlineSavingsMsg'
Learn More
Learn More
SIRT2 Mouse anti-Human, Mouse, Porcine, Rat, Clone: 1D8G10, Proteintech
Mouse Monoclonal Antibody
Brand: Proteintech 66410-1-IG-20UL
This item is not returnable.
View return policy
Description
The SIRT2 protein (also known as Sirtuin for Silent Mating Type Information 2-Homolog) is a NAD-dependent deacytylase (NDAC) that has been shown to control gene silencing, cell cycle, and DNA damage repair. It is believed that SIRT2 may act as a tumor suppressor in human gliomas and may also serve as a novel molecular marker for these cells. SIRT2 has also been shown to act as a redox sensor to help regulate muscle gene expression in response to food intake and exercise. SIRT2 acts in the phosphorylation cascade involving mitosis where SIRT2 is phosphorylated in late G2 phase, during M phase, and into cytokinesis.Specifications
| SIRT2 | |
| Monoclonal | |
| 1 mg/mL | |
| PBS with 50% glycerol and 0.02% sodium azide; pH 7.3 | |
| Q5RJQ4, Q8IXJ6, Q8VDQ8 | |
| Sirt2 | |
| SIRT2 Fusion Protein Ag7756 | |
| 20 μL | |
| Primary | |
| Human, Rat, Pig, Mouse | |
| Antibody | |
| IgG1 |
| Immunofluorescence, Immunohistochemistry (Paraffin), Immunocytochemistry, Western Blot | |
| 1D8G10 | |
| Unconjugated | |
| SIRT2 | |
| SIR2, SIR2 like protein 2, SIR2L, SIR2L2, SIRT2 | |
| Mouse | |
| Protein G | |
| RUO | |
| 100125964, 22933, 361532, 64383 | |
| -20°C | |
| Liquid |
Product Content Correction
Your input is important to us. Please complete this form to provide feedback related to the content on this product.
Product Title
Spot an opportunity for improvement?Share a Content Correction